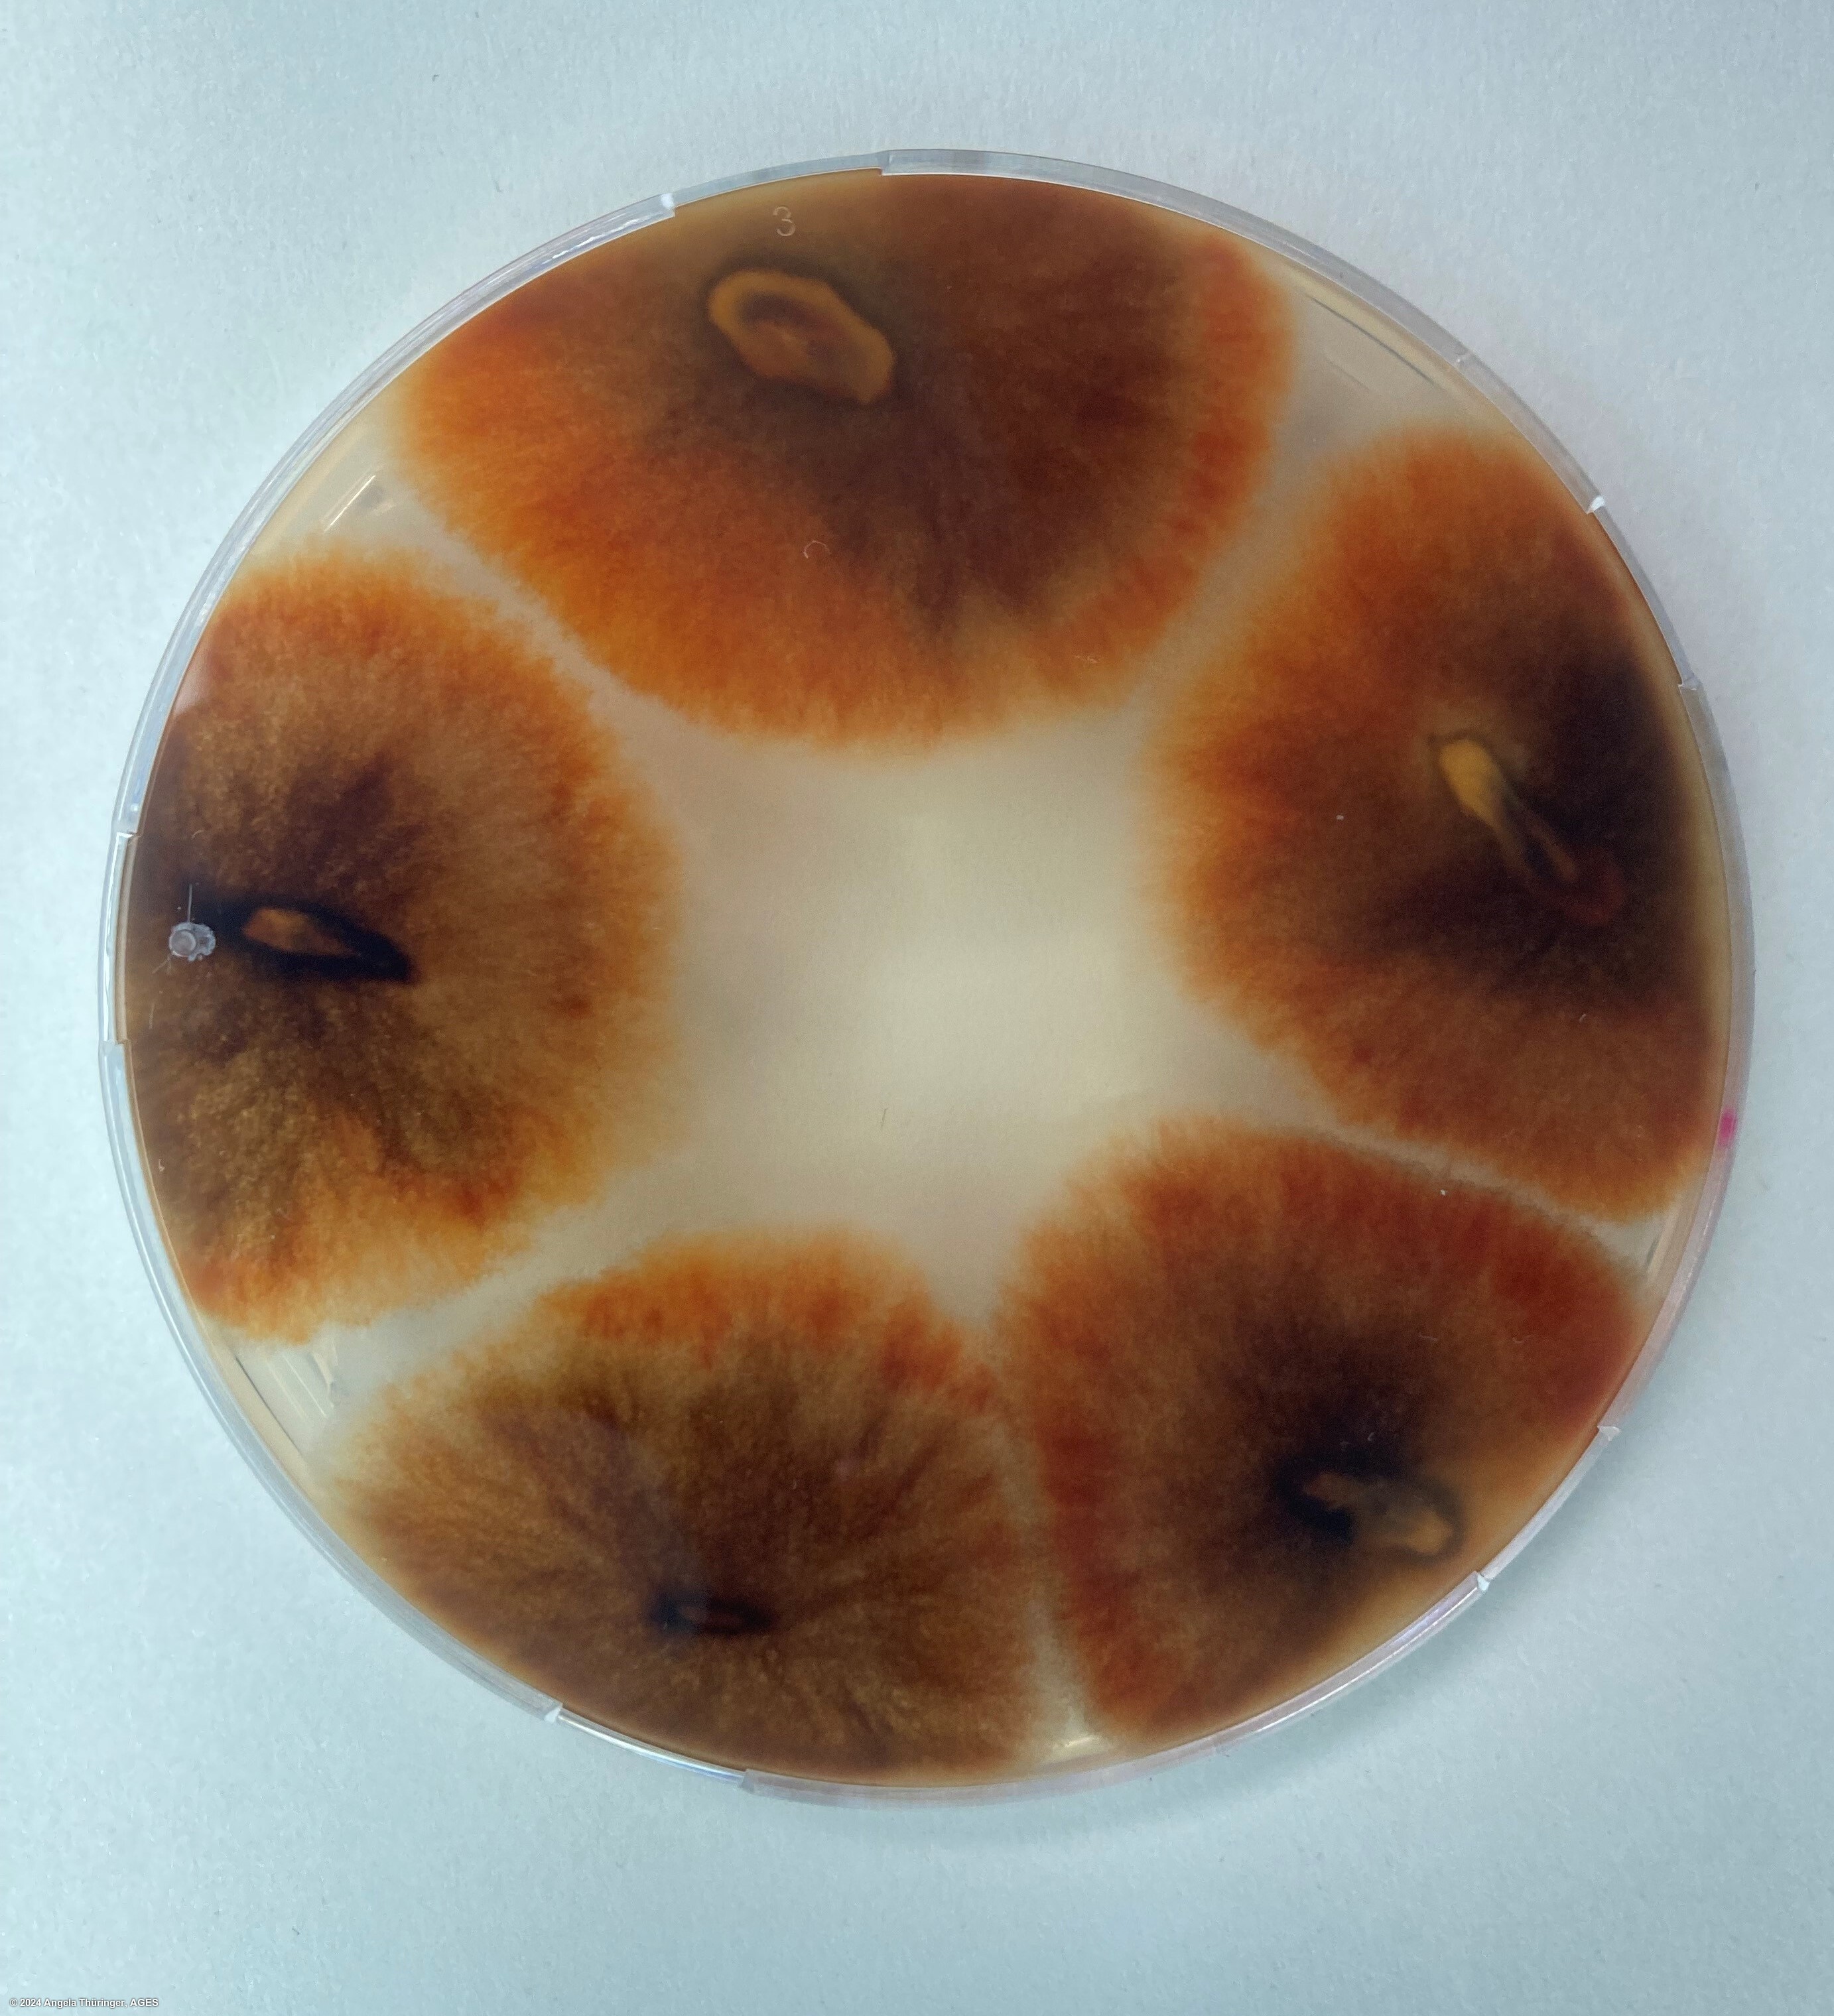
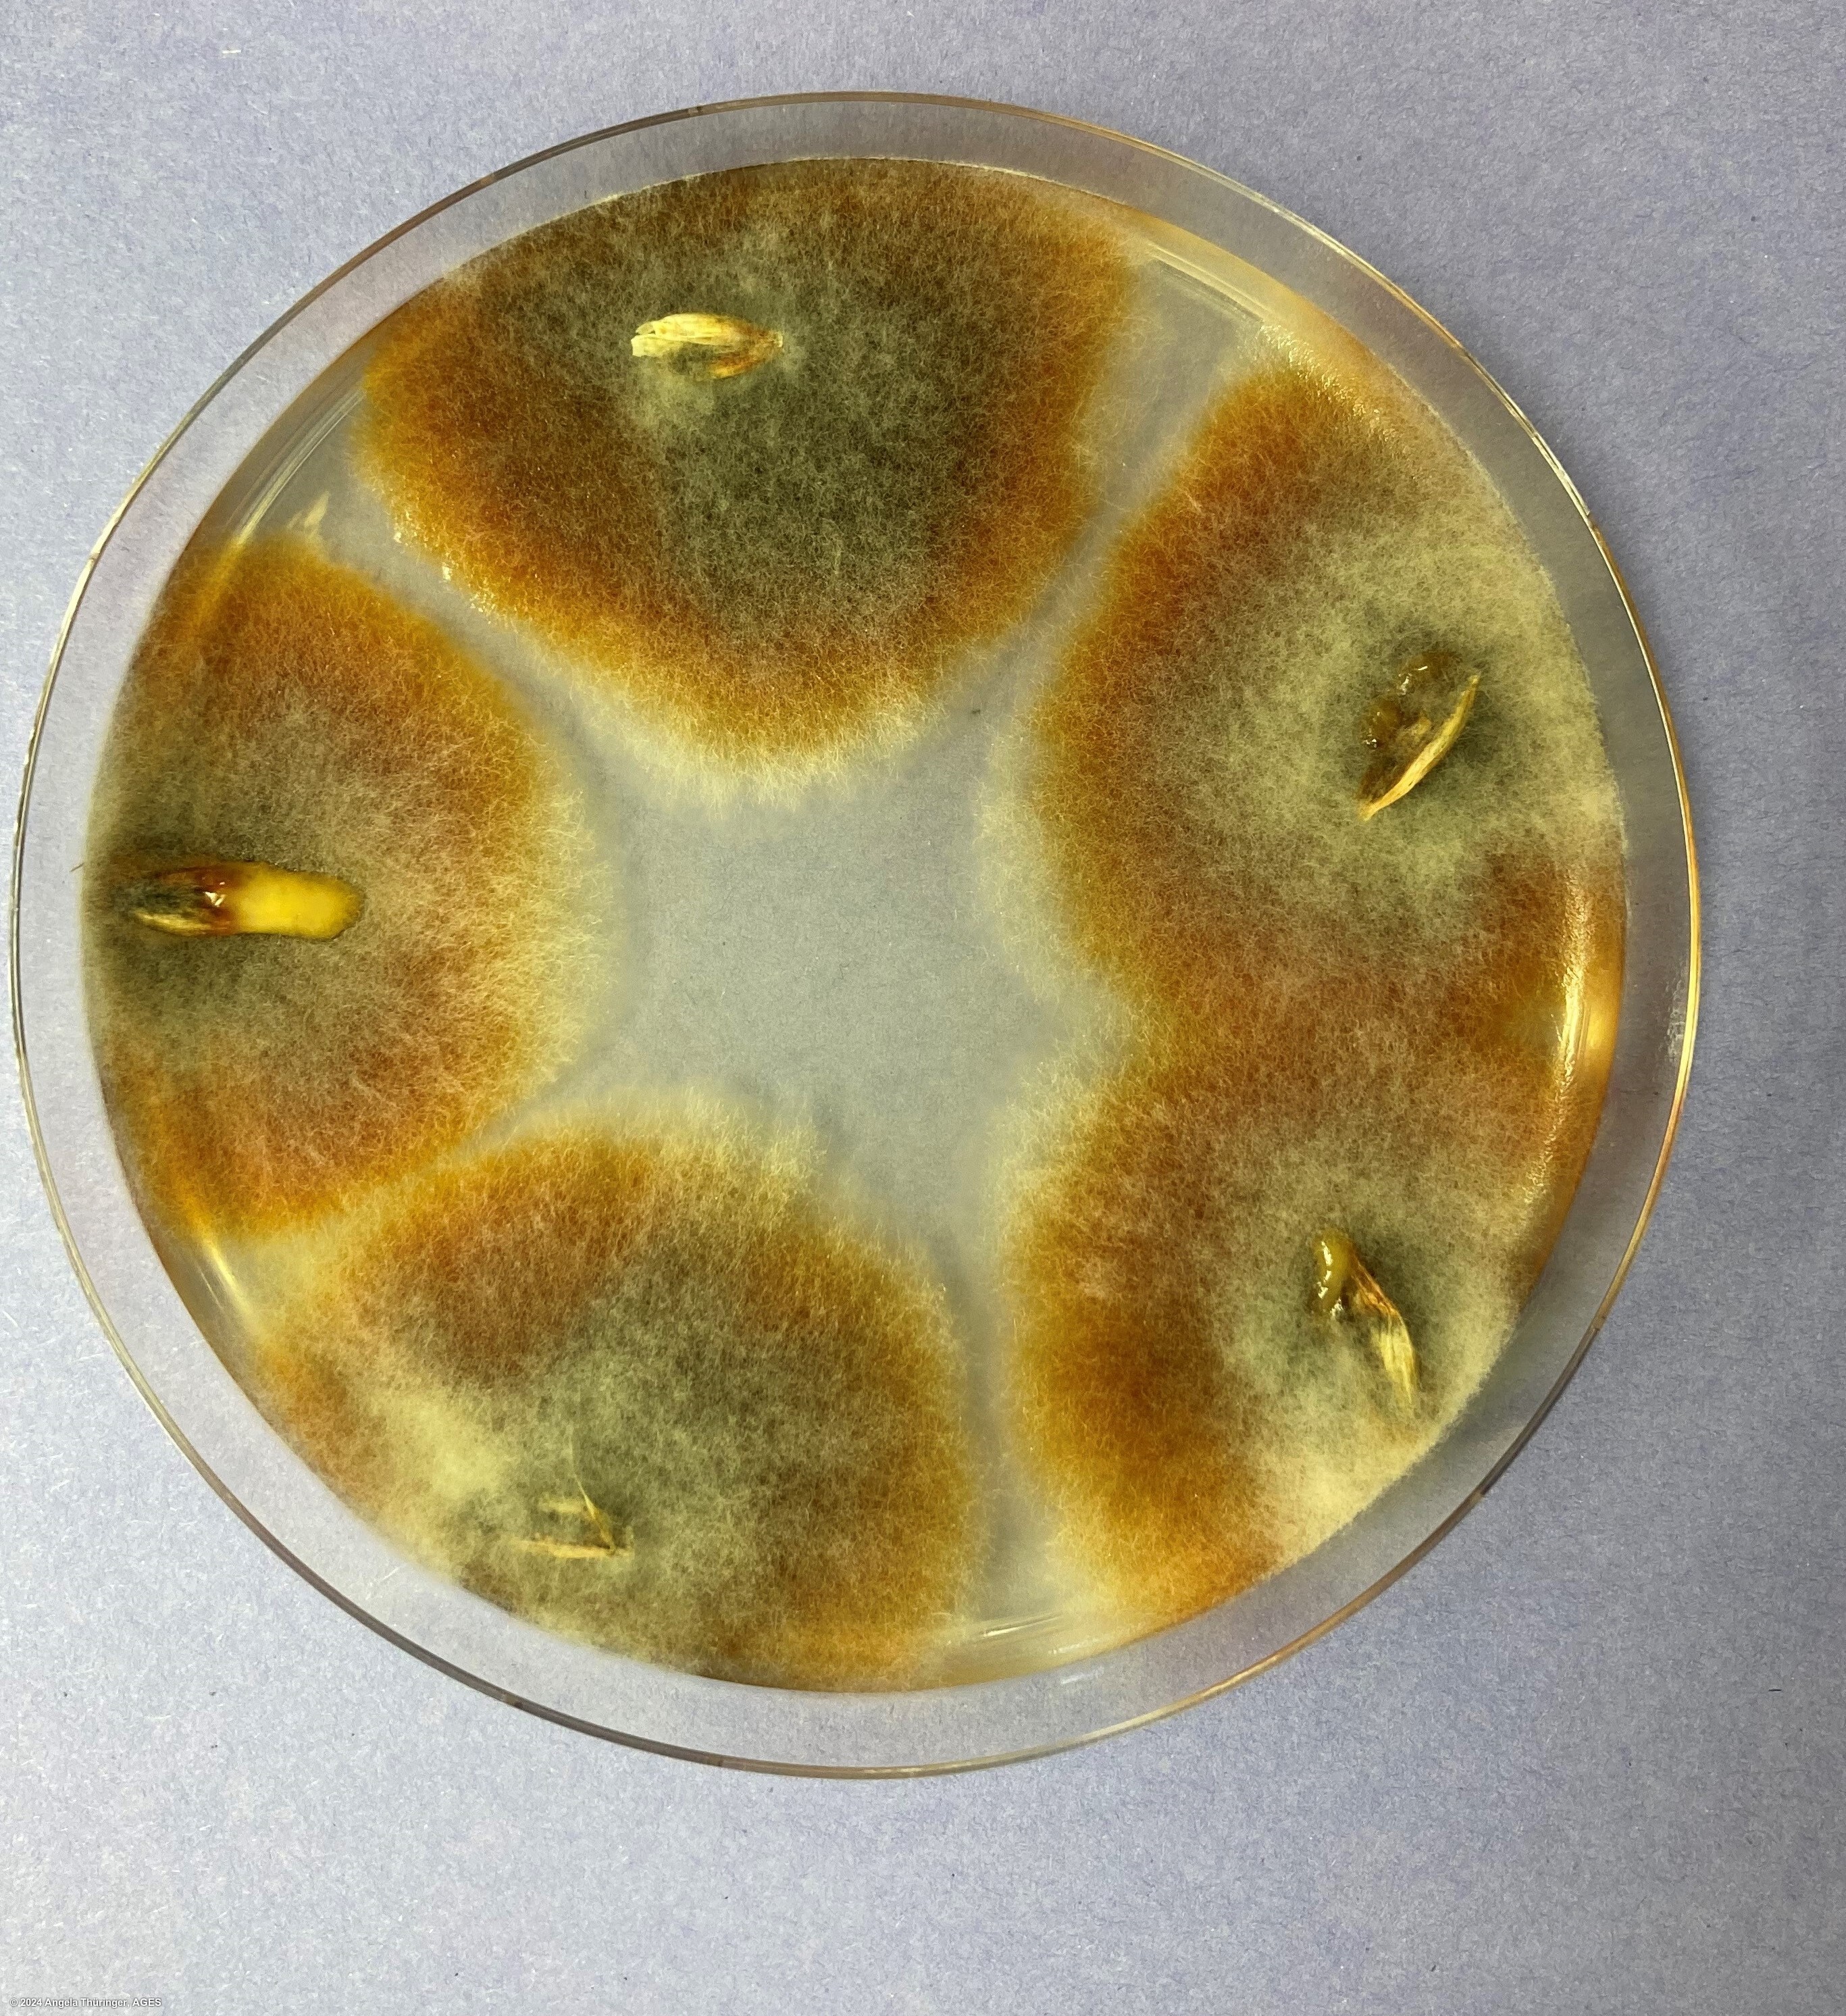
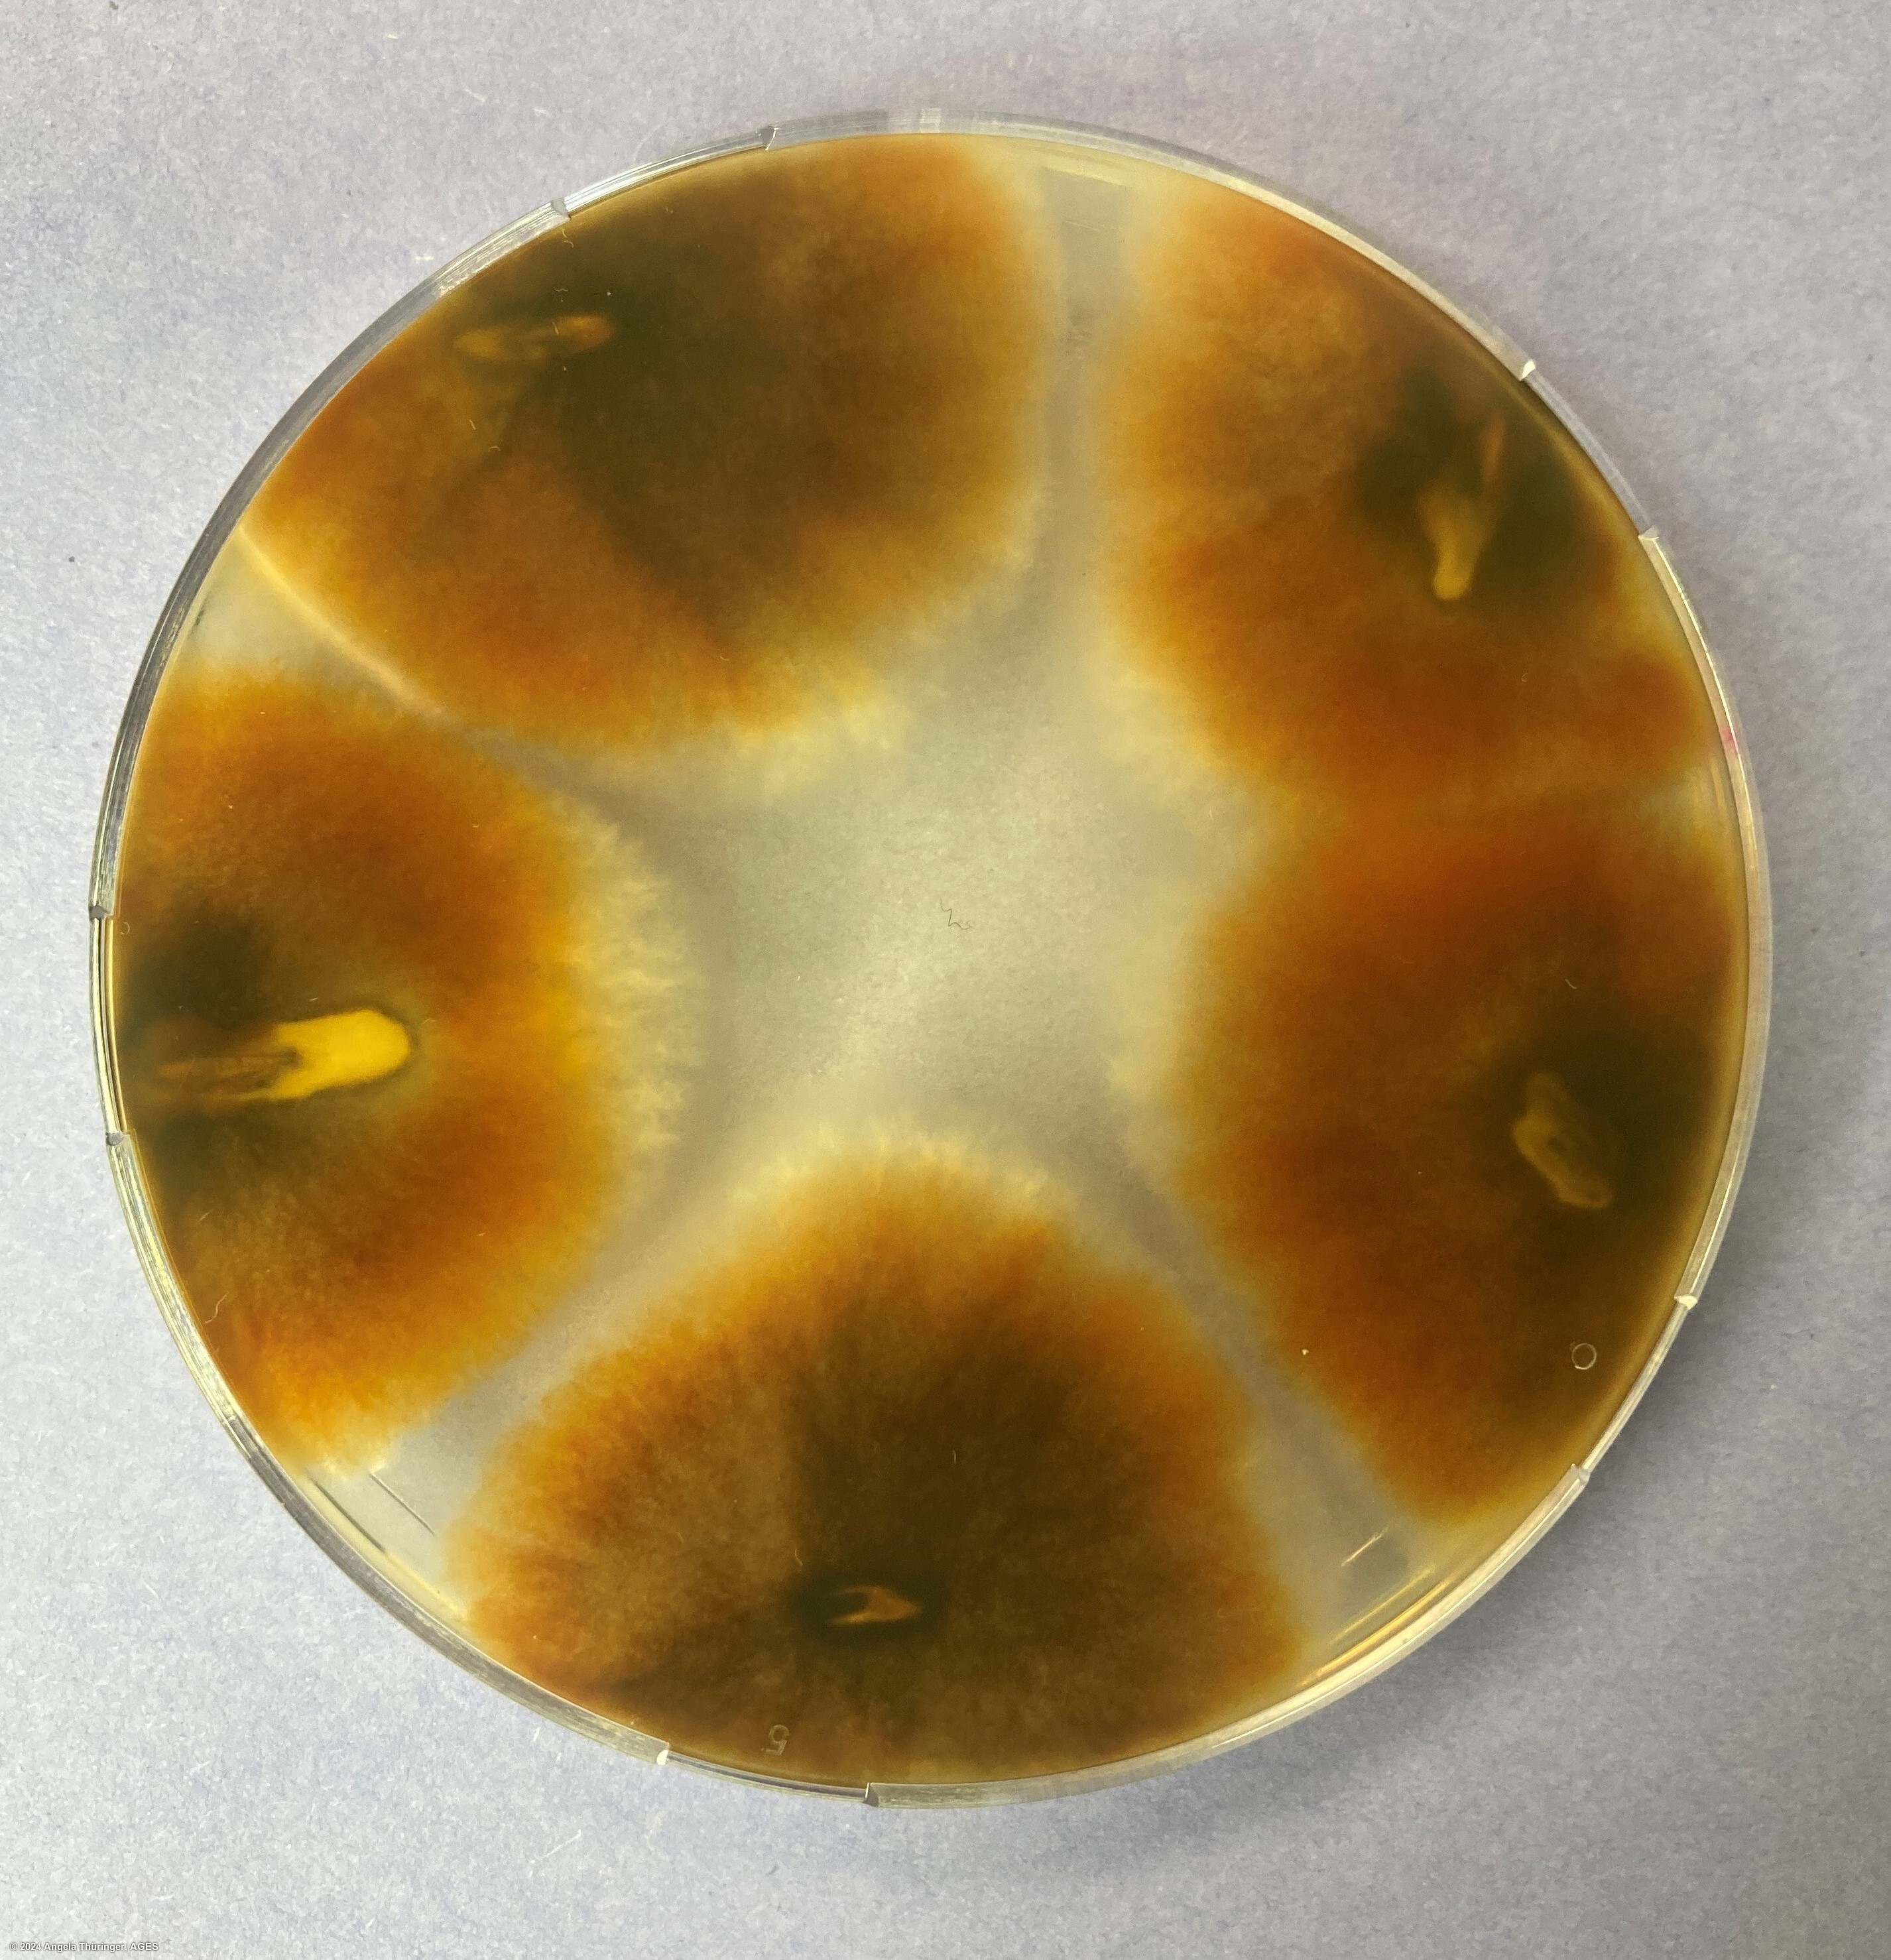
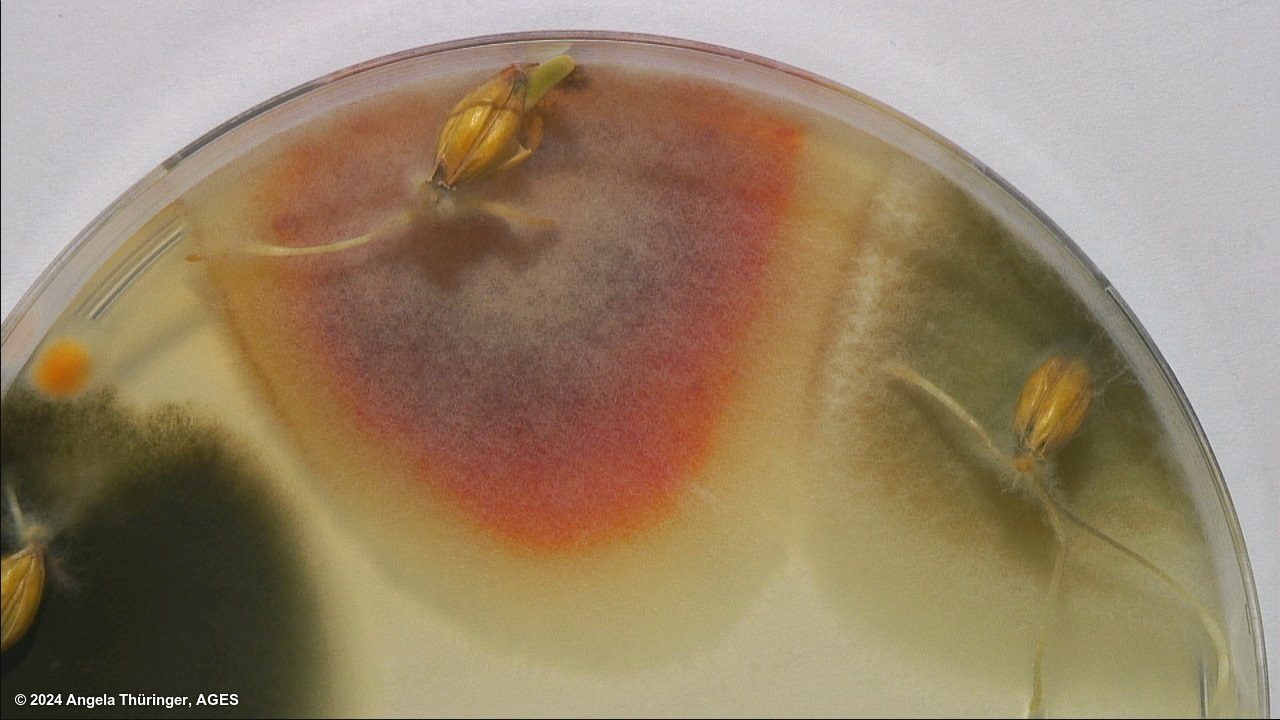

Submission
Pyrenophora graminea on Hordeum vulgare
- Credits / Owner: Angela Thüringer, AGES
- Submission date: 2024-06-20 13:16:11
- Submission ID: #41
Pathogen
|
Scientific name
|
Pyrenophora graminea |
|
Genus
|
Pyrenophora |
|
EPPO code
|
PYRNGR |
|
Common name
|
Barley leaf stripe |
|
Synonyms
|
Drechslera graminea |
|
Crop
|
Hordeum vulgare |
Submission
Description
Pyrenophora graminea colonies are big, bright or dark orange, look stringy in the back, sometimes they have a white edge around the colony.
| Sterilant: | 1% NaOCl |
| Sterilant time: | 10 min |
| Growth time: | 7 days |
| Lighting: | darkness |
| Agar: | PDA |
| Agar brand: | Merck |
| Sample origin: | Austria |